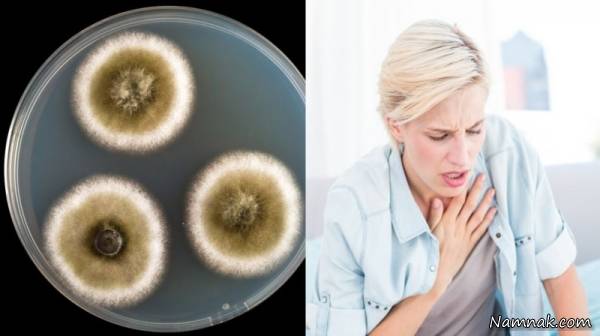

حالاتی که خبر از وجود قارچ در بدن انسان می دهد
کد مطلب : 55757زمان مطالعه : 2 دقیقه
نشانه های قارچ در بدن انسان را شناخته و جدی بگیرید ، اگر تغییراتی در دستگاه گوارش و تنفس یا حتی بینایی خود احساس کردید با داشتن برخی از علائم باید به وجود قارچ مشکوک شوید.
نشانه قارچها و باکتریهای سمی در بدن
ممکن است تا به حال همه ما در معرض قارچها و کپک ها بوده باشیم به خصوص در فضای داخل خانه پس بنابراین سعی کنید سینک ظرفشویی، حاشیه های خانه، پنجره های حمام را چک کنید. قارچ ها حتی زیر زمین و روی دیوار و سقف یاکابینت آشپزخانه می توانند رشد کنند. بهتر است برای شناخت نشانه های قارچ ابتدا با انواع آن آشنا شوید.
نشانه های وجود قارچ در بدن انسان
انواع قارچ هایی که سلامت بدن انسان را تهدید می کنند
قارچ های آلرژی زا
این قارچهامقداری خطرناک هستند و باعث مشکلاتی مثل آسم و حساسیت میشوند
قارچ های بیماری زا
این قارچها بیماری ایجاد میکند بنابراین سیستم ایمنی بدن را ضعیف کرده
قارچ های سمی
این قارچ سمی و خطرناک است وباسرطان ارتباط دارد وقتی فردی آن را بخورد لمس کند یا ببویدمشکلاتی ایجاد می کند
کپک سیاه
سریع عکس العمل نشان می دهد و در دهان بینی بالای تارهای تنفسی یافت می شود
آسپرژیلوس
منجر به آلودگی ریه می شود و در گرد و خاک منازل و محیط های گرم رشد می کنند
کپک سبز سیاه
این کپک معمولا باعث اسم زکام می شودودر چوب و ماده های مرطوب و نفوذ پذیر وجود دارد
پنی سیلین
این قارچ معمولا در کف پوشها بافت های پوسیده و کانال های فایبرگلس رشد می کنند و موجب حساسیت واسم می شود پنی سیلین ضد میکروبی یکی ازحیوان هایی است که میکو تکسین تولید می کند
استاکی بوتریس
این قارچ بسیار خطرناک است وکپک سیاه میکوتکسین ایجاد میکندکه باعث مشکلات مختلفی روی ریه وتنفس می شود این قارچ در کاغذ و چوب وجود دارد
قارچ ها باعث عفونت خارش و سم میشود عفونت که بر اثر قارچ ایجاد می شود به ترتیب باعث آنفلانزا مشکلات پوستی و ذات الریه می شود
10بیماری که نشانه وجود قارچ و میکروب های خطرناک در بدن است
علائم و بیماری های ناشی از قارچ در بدن
تشنگی شدید و ادرار زیاد
مشکلاتی در تمرکز و حافظه
اختلال در عملکرد مغز
مشکلات چشمی و قرمزی چشم یا تاری دید
آسم و مشکلات سینوسی
تنفس های کوتاه
مزه فلزی دهان
مشکلات هضم مثل :
شکم درد
اسهال
گرفتگی ماهیچه ها
لرزش وسرگیجه

10 حالت که خبر از وجود فلزات سمی در بدن می دهد
حمام های طولانی مدت خبر بدی ازشما می دهد
فاجعه ای که بعد پرخوری داخل بدن رخ می دهد
تغییری که 10 سال دیگر در بدن شما رخ می دهد
انسان هایی با اعضای بدن اضافه
اثرات فوق العاده تغذیه سالم روی سلامت بدن انسان
نشانه های علمی که خبر از عاشق شدن می دهد
دقایقی بعد خوردن پیتزا در بدن چه خبر می شود ؟